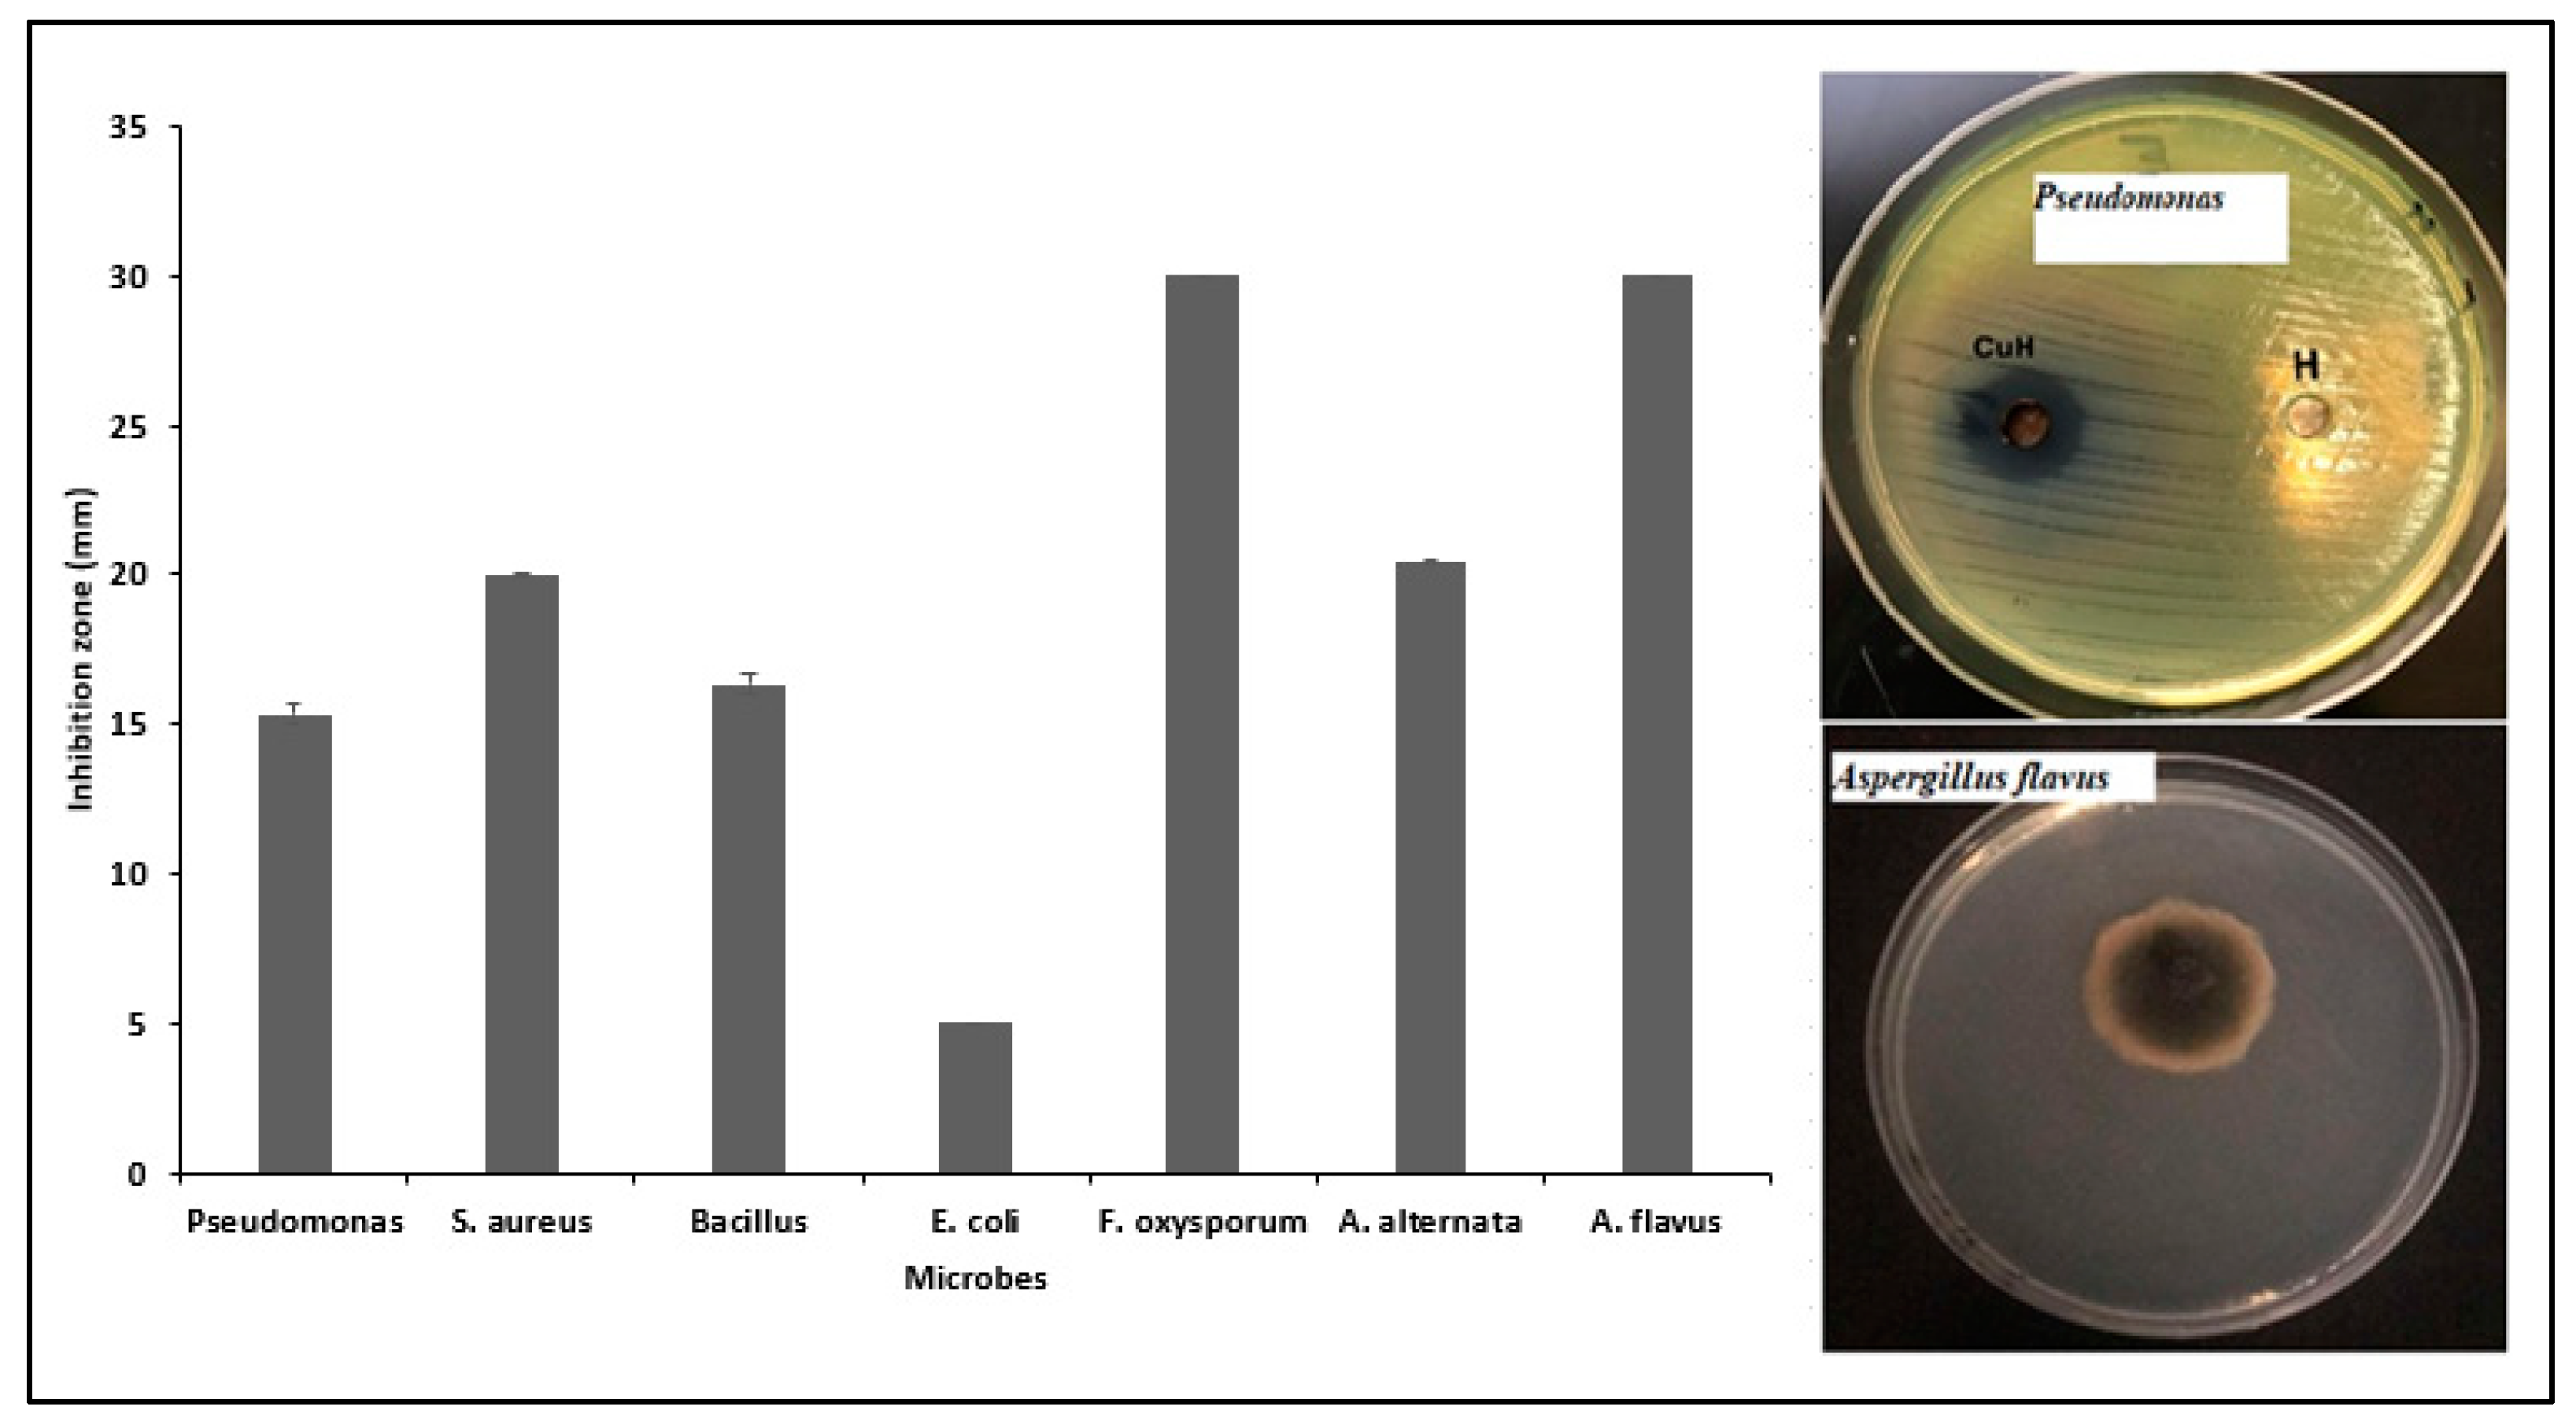
Catalysts 14 00800 g009 Catalysts 14 00800 g009

Fabrication of Multifunctional Green-Synthesized Copper Oxide Nanoparticles Using Rumex vesicarius L. Leaves for Enhanced Photocatalytic and Biomedical Applications
Abstract
1. Introduction
2. Results and Discussion
2.1. Analysis of the Optical Properties of Synthesized CuO NPs
2.2. Dynamic Light Scattering (DLS) Measurements
2.3. TEM and HR-TEM Analysis of Synthesized CuO NPs
2.4. Structural Analysis of Synthesized CuO NPs
2.5. EDX Analysis of Synthesized CuO NPs
2.6. Cytotoxicity Assessments
2.7. Photodegradation Results
2.8. Evaluation of the Antimicrobial Activity of Synthesized CuO NPs
3. Materials and Methods
3.1. Preparation of Rumex vesicarius L. Extract
3.2. Preparation of Copper Oxide Nanoparticles
3.3. Characterization of the Copper Oxide Nanoparticles
3.4. Anticancer Activities of the Copper Oxide Nanoparticles
3.5. Photodegradation of Dyes by Copper Oxide Nanoparticles
3.6. Antibacterial Activities of the Copper Oxide Nanoparticles
3.7. Statistical Analysis
4. Conclusions
Author Contributions
Funding
Data Availability Statement
Acknowledgments
Conflicts of Interest
References
- Bayda, S.; Adeel, M.; Tuccinardi, T.; Cordani, M.; Rizzolio, F. The history of nanoscience and nanotechnology: From chemical–physical applications to nanomedicine. Molecules 2019, 25, 112. [Google Scholar] [CrossRef] [PubMed]
- Sarma, I.D.; Bhowmick, D.; Bhilkar, P.; Sharma, R.; Chaudhary, R.G.; Sarma, I.D.; Chaudhary, R.G. Nanotechnology: Fundamental Aspects and Biomedical and Technological Applications. Nanobiomater. Perspect. Med. Appl. Diagn. Treat. Dis. 2023, 145, 1–18. [Google Scholar]
- Radulescu, D.M.; Surdu, V.A.; Ficai, A.; Ficai, D.; Grumezescu, A.M.; Andronescu, E. Green synthesis of metal and metal oxide nanoparticles: A review of the principles and biomedical applications. Int. J. Mol. Sci. 2023, 24, 15397. [Google Scholar] [CrossRef]
- Burlec, A.F.; Corciova, A.; Boev, M.; Batir-Marin, D.; Mircea, C.; Cioanca, O.; Danila, G.; Danila, M.; Bucur, A.F.; Hancianu, M. Current overview of metal nanoparticles’ synthesis, characterization, and biomedical applications, with a focus on silver and gold nanoparticles. Pharmaceuticals 2023, 16, 1410. [Google Scholar] [CrossRef]
- Chavali, M.S.; Nikolova, M.P. Metal oxide nanoparticles and their applications in nanotechnology. SN Appl. Sci. 2019, 1, 607. [Google Scholar] [CrossRef]
- Ashour, M.; Mansour, A.T.; Abdelwahab, A.M.; Alprol, A.E. Metal oxide nanoparticles’ green synthesis by plants: Prospects in phyto-and bioremediation and photocatalytic degradation of organic pollutants. Processes 2023, 11, 3356. [Google Scholar] [CrossRef]
- Renuga, D.; Jeyasundari, J.; Shakthi, A.S.; Brightson Arul Jacob, Y. Synthesis and Characterization of Copper Oxide Nanoparticles Using Brassica oleracea var. Italic Extract for Its Antifungal Application. Mater. Res. Express 2020, 7, 045007. [Google Scholar] [CrossRef]
- Safeyah Al-Shehri, N.A.S.; Altuwirqi, R.; Bayahya, A.; Al-Shammari, F.; Wang, Z.; Hala, A.J. Green Synthesis of CuxO Nanoscale MOS Capacitors Processed at Low Temperatures. Surf. Coat. Technol. 2017, 320, 246–251. [Google Scholar] [CrossRef][Green Version]
- Mali, S.C.; Dhaka, A.; Sharma, S.; Trivedi, R. Review on biogenic synthesis of copper nanoparticles and its potential applications. Inorg. Chem. Commun. 2023, 149, 110448. [Google Scholar] [CrossRef]
- Ganesan, K.; Jothi, V.K.; Natarajan, A.; Rajaram, A.; Ravichandran, S.; Ramalingam, S. Green Synthesis of Copper Oxide Nanoparticles Decorated with Graphene Oxide for Anticancer Activity and Catalytic Applications. Arab. J. Chem. 2020, 13, 6802–6814. [Google Scholar] [CrossRef]
- Rafique, M.; Tahir, M.B.; Irshad, M.; Nabi, G.; Gillani, S.S.A.; Iqbal, T.; Mubeen, M. Novel Citrus aurantifolia Leaves Based Biosynthesis of Copper Oxide Nanoparticles for Environmental and Wastewater Purification as an Efficient Photocatalyst and Antibacterial Agent. Optik 2020, 219, 165138. [Google Scholar] [CrossRef]
- Vennila, S. Eco-Friendly Synthesis of Metal Oxide Nanoparticles Using Carissa Carandas fruit extract. World J. Pharm. Res. 2016, 5, 806–812. [Google Scholar]
- Rajesh, K.M.; Ajitha, B.; Reddy YA, K.; Suneetha, Y.; Reddy, P.S. Assisted Green Synthesis of Copper Nanoparticles Using Syzygium aromaticum Bud Extract: Physical, Optical and Antimicrobial Properties. Optik 2018, 154, 593–600. [Google Scholar] [CrossRef]
- Benguigui, M.; Weitz, I.S.; Timaner, M.; Kan, T.; Shechter, D.; Perlman, O.; Sivan, S.; Raviv, Z.; Azhari, H.; Shaked, Y. Copper Oxide Nanoparticles Inhibit Pancreatic Tumor Growth Primarily by Targeting Tumor Initiating Cells. Sci. Rep. 2019, 9, 12613. [Google Scholar] [CrossRef]
- Sankar, R.; Maheswari, R.; Karthik, S.; Shivashangari, K.S.; Ravikumar, V. Anticancer Activity of Ficus religiosa Engineered Copper Oxide Nanoparticles. Mater. Sci. Eng. C Mater. Biol. Appl. 2014, 44, 234–239. [Google Scholar] [CrossRef]
- Luque-Jacobo, C.M.; Cespedes-Loayza, A.L.; Echegaray-Ugarte, T.S.; Cruz-Loayza, J.L.; Cruz, I.; de Carvalho, J.C.; Goyzueta-Mamani, L.D. Biogenic synthesis of copper nanoparticles: A systematic review of their features and main applications. Molecules 2023, 28, 4838. [Google Scholar] [CrossRef]
- Wang, W.; Zhu, Y.; Cheng, G.; Huang, Y. Microwave-Assisted Synthesis of Cupric Oxide Nanosheets and Nanowhiskers. Mater. Lett. 2006, 60, 609–612. [Google Scholar] [CrossRef]
- Kannan, S.K.; Sundrarajan, M. Biosynthesis of Yttrium Oxide Nanoparticles Using Acalypha indica Leaf Extract. Bull. Mater. Sci. 2015, 38, 945–950. [Google Scholar] [CrossRef]
- Muhammad, A.; Umar, A.; Birnin-Yauri, A.U.; Sanni, H.A.; Elinge, C.M.; Ige, A.R.; Ambursa, M.M. Green synthesis of copper nanoparticles using Musa acuminata aqueous extract and their antibacterial activity. Asian J. Trop. Biotechnol. 2023, 20. [Google Scholar]
- Manjari, G.; Saran, S.; Arun, T.; Vijaya Bhaskara Rao, A.V.B.; Devipriya, S.P. Catalytic and Recyclability Properties of Phytogenic Copper Oxide Nanoparticles Derived from Aglaia elaeagnoidea Flower Extract. J. Saudi Chem. Soc. 2017, 21, 610–618. [Google Scholar] [CrossRef]
- Kerour, A.; Boudjadar, S.; Bourzami, R.; Allouche, B. Eco-Friendly Synthesis of Cuprous Oxide (Cu2O) Nanoparticles and Improvement of Their Solar Photocatalytic Activities. J. Solid State Chem. 2018, 263, 79–83. [Google Scholar] [CrossRef]
- Murthy, H.A.; Abebe, B.; Prakash, C.H.; Shantaveerayya, K. A review on green synthesis of Cu and CuO nanomaterials for multifunctional applications. Mater. Sci. Res. India 2018, 15, 279–295. [Google Scholar] [CrossRef]
- Praburaman, L.; Jang, J.S.; Muthusamy, G.; Arumugam, S.; Manoharan, K.; Cho, K.M.; Min, C.; Kamala-Kannan, S.; Byung-Taek, O. Piper Betle-Mediated Synthesis, Characterization, Antibacterial and Rat Splenocyte Cytotoxic Effects of Copper Oxide Nanoparticles. Artif. Cells Nanomed. Biotechnol. 2016, 44, 1400–1405. [Google Scholar] [CrossRef]
- Sankar, R.; Manikandan, P.; Malarvizhi, V.; Fathima, T.; Shivashangari, K.S.; Ravikumar, V. Green Synthesis of Colloidal Copper Oxide Nanoparticles using Carica Papaya and its Application in Photocatalytic Dye Degradation. Spectrochim. Acta A Mol. Biomol. Spectrosc. 2014, 121, 746–750. [Google Scholar] [CrossRef]
- Saleh, N.A.M.; El-Hadidi, M.N.; Arafa, R.F.M. Flavonoids and Anthraquinones of Some Egyptian Rumex species (Polygonaceae). Biochem. Syst. Ecol. 1993, 21, 301–303. [Google Scholar] [CrossRef]
- Verma, K.K.; Gautam, R.K.; Choudhary, A.; Gupta, G.D.; Singla, S.; Goyal, S. A Review on Ethnobotany, Phytochemistry and Pharmacology on Rumex hastatus. Res. J. Pharm. Technol. 2020, 13, 26. [Google Scholar] [CrossRef]
- Harley, R.M. Flora of Eastern Saudi-Arabia–Mandaville, Jp Tls. Times 1991, 4598, 20. [Google Scholar]
- Farooq, M.; Abutaha, N.; Mahboob, S.; Baabbad, A.; Almoutiri, N.D.; Wadaan, M.A.A. Investigating the Antiangiogenic Potential of Rumex vesicarius (Humeidh), Anticancer Activity in Cancer Cell Lines and Assessment of Developmental Toxicity in Zebrafish Embryos. Saudi J. Biol. Sci. 2020, 27, 611–622. [Google Scholar] [CrossRef] [PubMed]
- Vasas, A.; Orbán-Gyapai, O.; Hohmann, J. The Genus Rumex: Review of Traditional Uses, Phytochemistry and Pharmacology. J. Ethnopharmacol. 2015, 175, 198–228. [Google Scholar] [CrossRef]
- Aldalbahi, A.; Aldawish, R.; Awad, M.A.G.; Aldosari, N.S.; Alshathri, R.H.; Aldwihi, L.A.; Alammari, R.; Shoqiran, K.I.B. Synthesis of Copper Oxide Nanoparticles. U.S. Patent 10,995,010 B1, 4 May 2021. [Google Scholar]
- Udayabhanu; Nethravathi, P.C.; Pavan Kumar, M.A.; Suresh, D.; Lingaraju, K.; Rajanaika, H.; Nagabhushana, H.; Sharma, S.C. Tinospora cordifolia Mediated Facile Green Synthesis of Cupric Oxide Nanoparticles and Their Photocatalytic, Antioxidant and Antibacterial Properties. Mater. Sci. Semicond. Process. 2015, 33, 81–88. [Google Scholar]
- Saif, S.; Tahir, A.; Asim, T.; Chen, Y. Plant Mediated Green Synthesis of CuO Nanoparticles: Comparison of Toxicity of Engineered and Plant Mediated CuO Nanoparticles Towards Daphnia magna. Nanomaterials 2016, 1, 205. [Google Scholar] [CrossRef] [PubMed]
- Monte-Filho, S.S.; Andrade, S.I.E.; Lima, M.B.; Araujo, M.C.U. Synthesis of Highly Fluorescent Carbon Dots from Lemon and Onion Juices for Determination of Riboflavin in Multivitamin/Mineral Supplements. J. Pharm. Anal. 2019, 9, 209–216. [Google Scholar] [CrossRef] [PubMed]
- Sukumar, S.; Rudrasenan, A.; Padmanabhan Nambiar, D. Green-Synthesized Rice-Shaped Copper Oxide Nanoparticles Using Caesalpinia bonducella Seed Extract and Their Applications. ACS Omega 2020, 5, 1040–1051. [Google Scholar] [CrossRef] [PubMed]
- Vasantharaj, S.; Sathiyavimal, S.; Saravanan, M.; Senthilkumar, P.; Gnanasekaran, K.; Shanmugavel, M.; Manikandan, E.; Pugazhendhi, A. Synthesis of Ecofriendly Copper Oxide Nanoparticles for Fabrication over Textile Fabrics: Characterization of Antibacterial Activity and Dye Degradation Potential. J. Photochem. Photobiol. B Biol. 2019, 191, 143–149. [Google Scholar] [CrossRef] [PubMed]
- Salopek, B.; Krasic, D.; Filipovic, S. Measurement and Application of Zeta-Potential. Rud. Geol. Naft. Zb. 1992, 4, 147. [Google Scholar]
- Muthuvel, A.; Jothibas, M.; Manoharan, C. Synthesis of Copper Oxide Nanoparticles by Chemical and Biogenic Methods: Photocatalytic Degradation and In Vitro Antioxidant Activity. Nanotechnol. Environ. Eng. 2020, 5, 14. [Google Scholar] [CrossRef]
- Dagher, S.; Haik, Y.; Ayesh, A.I.; Tit, N. Synthesis and Optical Properties of Colloidal CuO Nanoparticles. J. Lumin. 2014, 151, 149–154. [Google Scholar] [CrossRef]
- Talluri, B.; Prasad, E.; Thomas, T. Ultra-Small (r < 2 nm), Stable (>1 Year) Copper Oxide Quantum Dots with Wide Band Gap. Superlattices Microstruct. 2018, 113, 600–607. [Google Scholar] [CrossRef]
- Agam, M.A.; Awal, N.N.; Hassan, S.A.; Yabagi, J.A.; Qabel, M. Energy Band Gap Investigation of Polystyrene Copper Oxide Nanocomposites Bombarded with Laser. J. Adv. Res. Fluid Mech. Therm. Sci. 2020, 66, 125–135. [Google Scholar]
- Nemade, K.R.; Waghuley, S.A. Optical and Gas Sensing Properties of CuO Nanoparticles Grown by Spray Pyrolysis of Cupric Nitrate Solution. J. Mater. Sci. Eng. 2014, 2, 63–66. [Google Scholar] [CrossRef]
- Chen, J.S.; Mao, S.; Xu, Z.; Ding, W. Various Antibacterial Mechanisms of Biosynthesized Copper Oxide Nanoparticles Against Soilborne Ralstonia solanacearum. RSC Adv. 2019, 9, 3788–3799. [Google Scholar] [CrossRef] [PubMed]
- Murthy, H.C.A.; Desalegn, T.; Kassa, M.; Abebe, B.; Assefa, T. Synthesis of Green Copper Nanoparticles Using Medicinal Plant Hagenia abyssinica (Brace) JF. Gmel. Leaf Extr. Antimicrob. Prop. J. Nanomater. 2020, 12, 3924081. [Google Scholar] [CrossRef]
- Mishra, L.; Dwivedi, V.K.; Dara, H.K.; Chakradhary, V.K.; Ithineni, S.; Prabhudessai, A.G.; Nehar, S. Core/Shell-Like Magnetic Structure and Optical Properties in CuO Nanoparticles Synthesized by Green Route. ACS Sustain. Resour. Manag. 2024. [CrossRef]
- Vinardell, M.P.; Mitjans, M. Antitumor Activities of Metal Oxide Nanoparticles. Nanomaterials 2015, 5, 1004–1021. [Google Scholar] [CrossRef]
- Rehana, D.; Mahendiran, D.; Kumar, R.S.; Rahiman, A.K. Evaluation of Antioxidant and Anticancer Activity of Copper Oxide Nanoparticles Synthesized Using Medicinally Important Plant Extracts. Biomed. Pharmacother. 2017, 89, 1067–1077. [Google Scholar] [CrossRef] [PubMed]
- Nagajyothi, P.C.; Muthuraman, P.; Sreekanth, T.V.M.; Kim, D.H.; Shim, J. Green Synthesis: In-Vitro Anticancer Activity of Copper Oxide Nanoparticles against Human Cervical Carcinoma Cells. Arab. J. Chem. 2017, 10, 215–225. [Google Scholar] [CrossRef]
- Elemike, E.E.; Onwudiwe, D.C.; Singh, M. Eco-Friendly Synthesis of Copper Oxide, Zinc Oxide and Copper Oxide–Zinc Oxide Nanocomposites, and Their Anticancer Applications. J. Inorg. Organomet. Polym. Mater. 2020, 30, 400–409. [Google Scholar] [CrossRef]
- Sharma, M.; Sharma, A.; Majumder, S. Synthesis, Microbial Susceptibility and Anti-Cancerous Properties of Copper Oxide Nanoparticles-Review. NANO Express 2020, 1, 012003. [Google Scholar] [CrossRef]
- Elavarasan, N.; Kokila, K.; Prakash, S.; Sujatha, V. Exploration of Bio-synthesized Copper Oxide Nanoparticles Using Pterolobium hexapetalum Leaf Extract by Photocatalytic Activity. J. Clust. Sci. 2019, 30, 1157–1168. [Google Scholar] [CrossRef]
- He, H.; Zou, Z.; Wang, B.; Xu, G.; Chen, C.; Qin, X.; Yu, C.; Zhang, J. Copper Oxide Nanoparticles Induce Oxidative DNA Damage and Cell Death via Copper Ion-Mediated P38 MAPK Activation in Vascular Endothelial Cells. Int. J. Nanomed. 2020, 15, 3291–3302. [Google Scholar] [CrossRef]
- Roy, K.; Ghosh, C.K.; Sarkar, C.K. Degradation of Toxic Textile Dyes and Detection of Hazardous Hg2+ by Low-Cost Bioengineered Copper Nanoparticles Synthesized Using Impatiens balsamina Leaf Extract. Mater. Res. Bull. 2017, 94, 257–262. [Google Scholar] [CrossRef]
- Rabiee, N.; Bagherzadeh, M.; Kiani, M.; Ghadiri, A.M.; Etessamifar, F.; Jaberizadeh, A.H.; Shakeri, A. Biosynthesis of Copper Oxide Nanoparticles with Potential Biomedical Applications. Int. J. Nanomed. 2020, 15, 3983–3999. [Google Scholar] [CrossRef] [PubMed]
- Balázs, N.; Mogyorósi, K.; Srankó, D.F.; Pallagi, A.; Alapi, T.; Oszkó, A.; Dombi, A.; Sipos, P. The Effect of Particle Shape on the Activity of Nanocrystalline TiO2 Photocatalystsin Phenol Decomposition. Appl. Catal. B 2008, 84, 356–362. [Google Scholar] [CrossRef]
- Lahmar, H.; Benamira, M.; Douafer, S.; Akika, F.Z.; Hamdi, M.; Avramova, I.; Trari, M. Photocatalytic Degradation of Crystal Violet Dye on the Novel CuCr2O4/SnO2 Hetero-System under Sunlight. Opt. Int. J. Light Electron. Opt. 2020, 219, 165042. [Google Scholar] [CrossRef]
- Vivek, E.; Senthilkumar, N.; Pramothkumar, A.; Vimalan, M.; Potheher, I.V. Synthesis of Flower-Like Copper Oxide Microstructure and Its Photocatalytic Property. Phys. B Condens. Matter 2019, 566, 96–102. [Google Scholar] [CrossRef]
- Ansari, P.M.Y.; Muthukrishnan, R.M.; Khan, R.I.; Vedhi, C.; Sakthipandi, K.; Kader, S.A. Green synthesis of copper oxide nanoparticles using Amaranthus dubius leaf extract for sensor and photocatalytic applications. Chem. Phys. Impact 2023, 7, 100374. [Google Scholar] [CrossRef]
- Meena, J.; Kumaraguru, N.; Sami Veerappa, N.; Shin, P.K.; Tatsugi, J.; Kumar, A.S.; Santhakumar, K. Copper oxide nanoparticles fabricated by green chemistry using Tribulus terrestris seed natural extract-photocatalyst and green electrodes for energy storage device. Sci. Rep. 2023, 13, 22499. [Google Scholar] [CrossRef]
- Jayasimha, H.N.; Chandrappa, K.G.; Sanaulla, P.F.; Dileepkumar, V.G. Green synthesis of CuO nanoparticles: A promising material for photocatalysis and electrochemical sensor. Sens. Int. 2024, 5, 100254. [Google Scholar] [CrossRef]
- Sangeetha, A.; Abarna, B. Lemon peel assisted synthesis of copper oxide nanoparticles for photocatalytic degradation. Mater. Today Proc. 2023. [Google Scholar] [CrossRef]
- Ali, S.G.; Haseen, U.; Jalal, M.; Khan, R.A.; Alsalme, A.; Ahmad, H.; Khan, H.M. Green synthesis of copper oxide nanoparticles from the leaves of Aegle marmelos and their antimicrobial activity and photocatalytic activities. Molecules 2023, 28, 7499. [Google Scholar] [CrossRef]
- Taghavi Fardood, S.; Moradnia, F.; Heidarzadeh, S.; Naghipour, A. Green synthesis, characterization, photocatalytic and antibacterial activities of copper oxide nanoparticles of copper oxide nanoparticles. Nanochem. Res. 2023, 8, 134–140. [Google Scholar]
- Indhira, D.; Krishnamoorthy, M.; Ameen, F.; Bhat, S.A.; Arumugam, K.; Ramalingam, S.; Priyan, S.R.; Kumar, G.S. Biomimetic facile synthesis of zinc oxide and copper oxide nanoparticles from Elaeagnus indica for enhanced photocatalytic activity. Environ. Res. 2022, 212, 113323. [Google Scholar] [CrossRef]
- Mishra, U.K.; Chandel, V.S.; Yadav, A.K.; Gautam, A.K.; Anand, A.D.; Varun, J.; Rai, A.K.; Singh, S.P. Synthesis, characterization, and study of photocatalytic degradation of aniline blue dye using copper oxide nanoparticles prepared by Santa Maria feverfew leaf extract. Nanotechnol. Environ. Eng. 2024, 9, 1–10. [Google Scholar] [CrossRef]
- Relhan, A.; Guleria, S.; Bhasin, A.; Mirza, A.; Zhou, J.L. Biosynthesized copper oxide nanoparticles by Psidium guajava plants with antibacterial, antidiabetic, antioxidant, and photocatalytic capacity. Biomass Convers. Biorefin. 2024, 1–18.–18. [Google Scholar] [CrossRef]
- Alshehri, A.A.; Malik, M.A. Biogenic fabrication of ZnO nanoparticles using Trigonella foenum-graecum (Fenugreek) for proficient photocatalytic degradation of methylene blue under UV irradiation. J. Mater. Sci. Mater. Electron. 2019, 30, 16156–16173. [Google Scholar] [CrossRef]
- Awad, M.A.; Hendi, A.A.; Ortashi, K.M.; Alnamlah, R.A.; Alangery, A.; Ali Alshaya, E.; Alshammari, S.G. Utilizing Cymbopogon Proximus Grass Extract for Green Synthesis of Zinc Oxide Nanorod Needles in Dye Degradation Studies. Molecules 2024, 29, 355. [Google Scholar] [CrossRef]
- Avinash, B.; Ravikumar, C.R.; Basavaraju, N.; Abebe, B.; Kumar, T.N.; Manjula, S.N.; Murthy, H.A. Facile green synthesis of zinc oxide nanoparticles: Its photocatalytic and electrochemical sensor for the determination of paracetamol and D-glucose. Environ. Funct. Mater. 2023, 2, 133–141. [Google Scholar] [CrossRef]
- Hoon Seo, K.; Markus, J.; Soshnikova, V.; Oh, K.H.; Anandapadmanaban, G.; Elizabeth Jimenez Perez, Z.; Mathiyalagan, R.; Kim, Y.J.; Yang, D.C. Facile and green synthesis of zinc oxide particles by Stevia rebaudiana and its in vitro photocatalytic activity. Inorg. Nano-Met. Chem. 2019, 49, 1–6. [Google Scholar] [CrossRef]
- Singh, K.; Nancy Bhattu, M.; Singh, G.; Mubarak, N.M.; Singh, J. Light-absorption-driven photocatalysis and antimicrobial potential of PVP-capped zinc oxide nanoparticles. Sci. Rep. 2023, 13, 13886. [Google Scholar] [CrossRef]
- Ramasamy, K.; Dhavamani, S.; Natesan, G.; Sengodan, K.; Sengottayan, S.N.; Tiwari, M.; Vikram, S.S.; Perumal, V. A potential role of green engineered TiO2 nanocatalyst towards enhanced photocatalytic and biomedical applications. Environ. Sci. Pollut. Res. 2021, 28, 41207–41223. [Google Scholar] [CrossRef]
- Rathi, V.H.; Jeice, A.R. Green fabrication of titanium dioxide nanoparticles and their applications in photocatalytic dye degradation and microbial activities. Chem. Phys. Impact 2023, 6, 100197. [Google Scholar] [CrossRef]
- Muthuvel, A.; Said, N.M.; Jothibas, M.; Gurushankar, K.; Mohana, V. Microwave-assisted green synthesis of nanoscaled titanium oxide: Photocatalyst, antibacterial and antioxidant properties. J. Mater. Sci. Mater. Electron. 2021, 32, 23522–23539. [Google Scholar] [CrossRef]
- Sangchay, W.; Sikong, L.; Kooptarnond, K. Comparison of photocatalytic reaction of commercial P25 and synthetic TiO2-AgCl nanoparticles. Procedia Eng. 2012, 32, 590–596. [Google Scholar] [CrossRef]
- Akl, M.A.; Mohammad, W.A. Biosynthesis of Copper Oxide Nanoparticles Using Ailanthus altissima Leaf Extract and Antibacterial Activity. Chem. Int. 2020, 6, 113–114. [Google Scholar]
- Bhavyasree, P.G.; Xavier, T.S. Green Synthesis of Copper Oxide/Carbon Nanocomposites Using the Leaf Extract of Adhatoda vasica Nees, Their Characterization and Antimicrobial Activity. Heliyon 2020, 6, e03323. [Google Scholar] [CrossRef]
- Hasheminya, S.M.; Dehghannya, J. Green synthesis and characterization of copper nanoparticles using Eryngium caucasicum Trautv aqueous extracts and its antioxidant and antimicrobial properties. Part. Sci. Technol. 2020, 38, 1019–1026. [Google Scholar] [CrossRef]
- Mali, S.C.; Dhaka, A.; Githala, C.K.; Trivedi, R. Green Synthesis of Copper Nanoparticles Using Celastrus paniculatus Willd. Leaf Extract and Their Photocatalytic and Antifungal Properties. Biotechnol. Rep. 2020, 27, e00518. [Google Scholar] [CrossRef]
- Gomaa, E.Z.; Housseiny, M.M.; Omran, A.A.A.K. Fungicidal Efficiency of Silver and Copper Nanoparticles Produced by Pseudomonas fluorescens ATCC 17397 Against Four Aspergillus species: A Molecular Study. J. Clust. Sci. 2019, 30, 181–196. [Google Scholar] [CrossRef]
- Pariona, N.; Mtz-Enriquez, A.I.; Sánchez-Rangel, D.; Carrión, G.; Paraguay-Delgado, F.; Rosas-Saito, G. Green-Synthesized Copper Nanoparticles as a Potential Antifungal against Plant Pathogens. RSC Adv. 2019, 9, 18835–18843. [Google Scholar] [CrossRef]

| Decolorization of Dye (%) | Irradiation Time (min) | Source of Light | Band Gap (eV) | Particles Size (nm)/Morphology | Nano-Material | Source of Plants |
|---|---|---|---|---|---|---|
| 84%/MB dye | 150 | Solar | 2.23 | 11/agglomerated shape | CuO NPs | Amaranthus dubius leaf [57] |
| 84.23%/methyl orange dye | 120 | Lamp | 3.1 | 58.7/spherical shape | CuO NPs | Tribulus terrestris seed [58] |
| 97.35%/AR88 dye | 80 | UV | 2.59 | 36/irregular morphology shape | CuO NPs | Arundinaria gigantea (giant cane) [59] |
| 72%/methyl orange dye | 240 | Sunlight | - | 27.99/less agglomeration | CuO NPs | Lemon peel [60] |
| 96%/MB and 99%/methyl orange dyes | 540 | Sunlight | 3.57 (330 nm) | 32/rectangular shape | CuO NPs | Aegle marmelos leaf [61] |
| 86%/RB21 dye | 60 | UV | 2.04 | 25/spherical shape | CuO NPs | Tragacanth gum [62] |
| 76%/MB dye | 240 | Sunlight | - | 30–40/agglomerated NPs | CuO NPs | Elaeagnus indica leaf [63] |
| 91%/aniline blue dye | 1000 | Sunlight | 3.56 | 20–80/spherical shapes | CuO NPs | Santa Maria feverfew [64] |
| 82.31%/MB dye and 88.54%/CV dye | 150 | UV | - | 15.88 nm/irregular surface shape | CuO NPs | Allahabad Safeda [65] |
| 88.37%/MB dye | 90 | UV | 2.97 | 55.73/fakes and irregular spherical shape | ZnO NPs | Trigonella foenum-graecum aqueous seed [66] |
| 97%/rhodamine B dye | 160 | UV | 3.6 | 35/nanorod needle shape | ZnO NPs | Cymbopogon proximus [67] |
| 75.8%/acid red-88 (AR-88) dye | 120 | UV | 2.79 | 30/irregular shape | ZnO NPs | Aloe vera latex [68] |
| 79%/MB dye | 30 | UV | 3.38 (366 nm) | 582.35 ± 52.40 nm/flower-shape | ZnO NPs | Stevia rebaudiana leaves [69] |
| 88%/red-141 azo dye | 120 | UV | 3.36 | 22.13/spherical shape | ZnO NPs | Chemical method [70] |
| 93.1%/CV dye, 90.6%/MB dye, 76.7%/methyl orange, 72.4%/alizarin red | 240 | UV | 3.58 | 36–81/spherical shape | TiO2 NPs | Ludwigia octovalvis [71] |
| 56%/MB | 40 | UV | 3.47 | 15–28/spherical morphology | TiO2 NPs | Nervilia aragoana leaf [72] |
| 97%/MB, 99%/methyl orange | 90 | Sunlight | 3.2 | 22/spherical shape | TiO2 NPs | Wrightia tinctoria [73] |
| 47% and 32%/MB | 240 | UV | - | 32.3/spherical shape | TiO2 NPs | Commercial P25 [74] |
| 92% CV dye, 99% MB dye | 36 h, and 12 h | UV | 3.52, 2.93 | 19.8/roughly spherical and irregular in shape | CuO NPs | Rumex vesicarius L. [current study] |
Disclaimer/Publisher’s Note: The statements, opinions and data contained in all publications are solely those of the individual author(s) and contributor(s) and not of MDPI and/or the editor(s). MDPI and/or the editor(s) disclaim responsibility for any injury to people or property resulting from any ideas, methods, instructions or products referred to in the content. |
© 2024 by the authors. Licensee MDPI, Basel, Switzerland. This article is an open access article distributed under the terms and conditions of the Creative Commons Attribution (CC BY) license (https://creativecommons.org/licenses/by/4.0/).
Share and Cite
Alterary, S.S.; Aldalbahi, A.; Aldawish, R.; Awad, M.A.; Ali Alshehri, H.; Ali Alqahtani, Z.; Alshathri, R.H.; Aldosari, N.S.; Aldwihi, L.A.; Mohsen Alsaggaf, S.; et al. Fabrication of Multifunctional Green-Synthesized Copper Oxide Nanoparticles Using Rumex vesicarius L. Leaves for Enhanced Photocatalytic and Biomedical Applications. Catalysts 2024, 14, 800. https://doi.org/10.3390/catal14110800
Alterary SS, Aldalbahi A, Aldawish R, Awad MA, Ali Alshehri H, Ali Alqahtani Z, Alshathri RH, Aldosari NS, Aldwihi LA, Mohsen Alsaggaf S, et al. Fabrication of Multifunctional Green-Synthesized Copper Oxide Nanoparticles Using Rumex vesicarius L. Leaves for Enhanced Photocatalytic and Biomedical Applications. Catalysts. 2024; 14(11):800. https://doi.org/10.3390/catal14110800
Chicago/Turabian StyleAlterary, Seham S., Ali Aldalbahi, Raneem Aldawish, Manal A. Awad, Hind Ali Alshehri, Zainah Ali Alqahtani, Reem Hamad Alshathri, Noura S. Aldosari, Leen Abdullah Aldwihi, Shorouq Mohsen Alsaggaf, and et al. 2024. "Fabrication of Multifunctional Green-Synthesized Copper Oxide Nanoparticles Using Rumex vesicarius L. Leaves for Enhanced Photocatalytic and Biomedical Applications" Catalysts 14, no. 11: 800. https://doi.org/10.3390/catal14110800
APA StyleAlterary, S. S., Aldalbahi, A., Aldawish, R., Awad, M. A., Ali Alshehri, H., Ali Alqahtani, Z., Alshathri, R. H., Aldosari, N. S., Aldwihi, L. A., Mohsen Alsaggaf, S., Shuqiran, K. I. B., B. Alammari, R., Ibrahim Alabdullah, B., Abdullah Aljaser, H., & Alzahly, S. (2024). Fabrication of Multifunctional Green-Synthesized Copper Oxide Nanoparticles Using Rumex vesicarius L. Leaves for Enhanced Photocatalytic and Biomedical Applications. Catalysts, 14(11), 800. https://doi.org/10.3390/catal14110800

